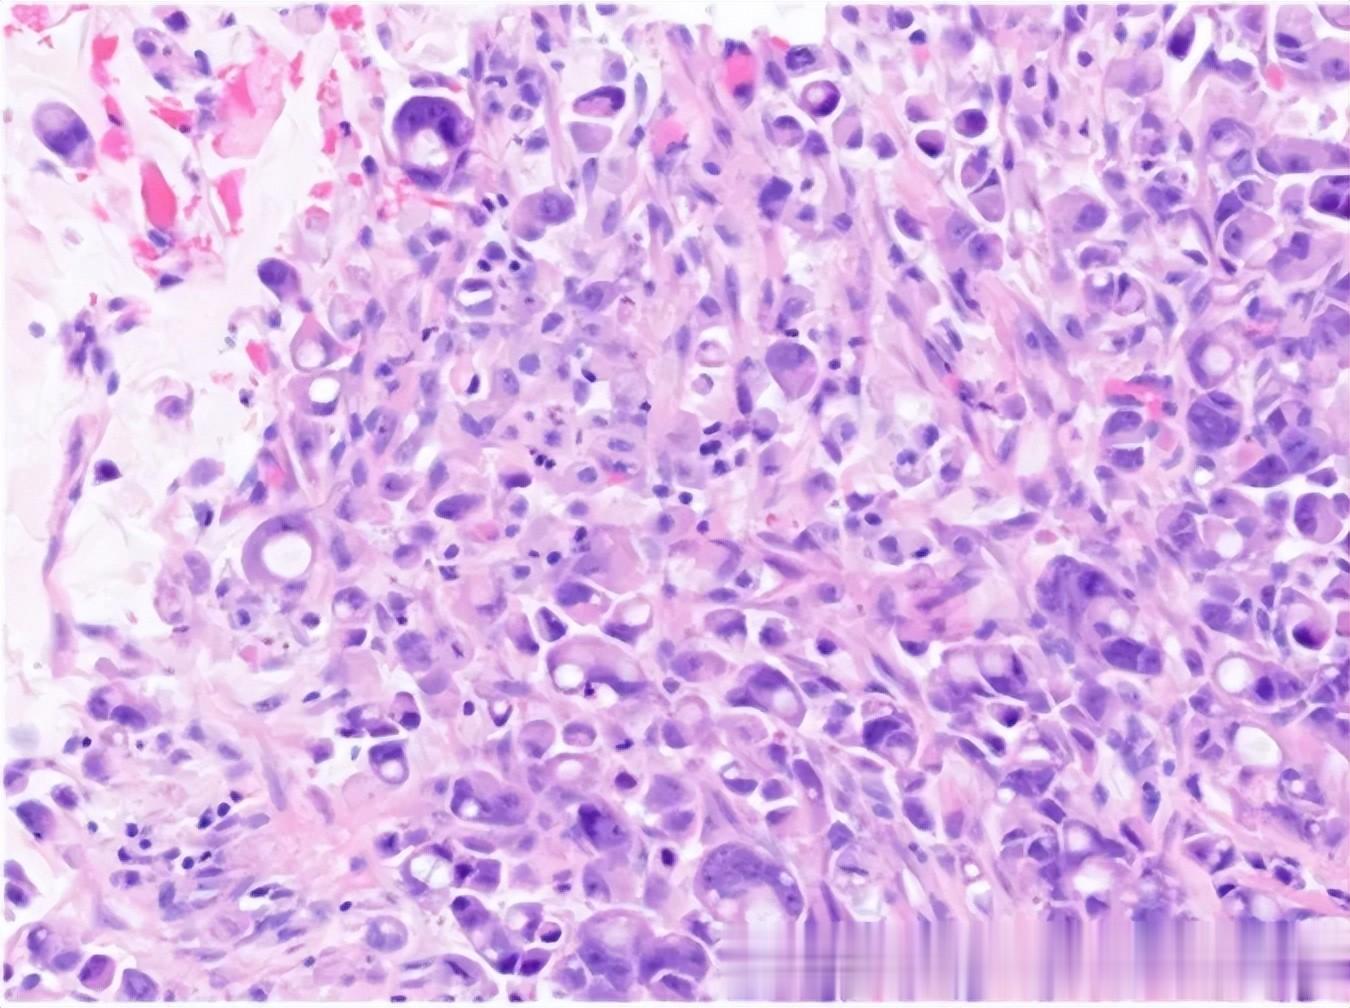

癌症手术后化疗是为了什么?
化疗的“通杀”特性就是为了将手术切除以外,看不见的残留癌细胞清除,防止它们在术后继续增殖,降低复发转移风险。
为什么有人手术后做了化疗还是转移了?
一定要警惕,有这几种特征的癌症都不好惹,化疗不一定能兜底!今天的主人公就是8个疗程后病情又进展,希望她的经历能给更多癌症患者和家属提个醒。
病情概述
2023年8月29日,罗女士在定期体检肝胆胰脾彩超时,发现胆囊区大小约6.9×2.6×1.8cm胆囊样回声,怀疑结石合并肝血管瘤。

2023年10月3日,罗女士就做了腹腔镜下胆囊切除术+腹腔镜下肝部分切除术+腹腔镜下肝病损射频消融术+肝门淋巴结清扫术+腹腔镜下肠粘连松解术。
*术后病理诊断:胆囊壁可见低分化腺癌弥漫浸润,呈低粘附性癌表现,局灶呈印戒细胞癌,肿瘤大小约3.2×2×1.5cm,浸润胆囊壁全层,可见广泛神经周围侵犯,未见明确脉管内癌栓。
*免疫组化染色结果:CK(+),CK7(+),CK19(+),MLH1 (+),PMS2(+),MSH2(+),MSH6(+),C-erbB-2(0),特殊染色结果:AB-PAS(+)。
两周后,2023年10月16日,罗女士再次手术,行胆囊癌根治术。
*术后病理回报:胆管壁组织可见纤维组织增生及慢性炎症、多核巨细胞反应,局灶神经束可见异型细胞浸润,符合低粘附性癌细胞侵犯神经;胆管壁外可见淋巴结,未见癌转移。

*首次术后TNM分期:T2bN0M0 IIB期。
根据术后辅助化疗方案,为降低复发转移风险,罗女士从2023年11月至2024年5月又进行了吉西他滨化疗8个疗程。
至此,罗女士的标准治疗方案已经结束,看似手术切除肿瘤+化疗收尾,是个很完整的治疗了。
但化疗结束3个月后,2024年7月的复查就出现了异常,肝左外叶环形强化灶,长径约11mm,转移不除外。
化疗还转移?这4种特征的癌症不好惹
1、低分化
肿瘤细胞的分化程度越低越危险,低分化肿瘤,就像“失控的野孩子”,它们结构混乱、核分裂活跃,低分化肿瘤常在早期就能“离家出走”,顺着淋巴或血液四处转移,风险显著高于中分化和高分化肿瘤。手术后容易出现局部复发或远处转移,整体生存率(OS)显著低于高分化组,预后较差。

2、低粘附性
简单来说就是癌细胞之间缺乏黏附蛋白的连接导致癌细胞“不抱团”、“一碰就散”,这就引发了癌细胞容易从原发灶脱落,像“逃犯”一样到处跑,溜进血液或淋巴系统,跑到肝、肺等其他器官。

3、印戒细胞癌
印戒样癌细胞的特点就是单个或呈条索状排列,粘附性差,在胆囊壁内呈弥漫性浸润,使胆囊呈现皮革样外观。部分传统的胆管型腺癌可能在局部表现出这种形态,此时肿瘤更具侵袭性。
(▲ 胆囊印戒细胞癌)
4、神经侵犯、脉管癌栓
如果说神经是身体里的电网,那血管和淋巴管就像身体里的交通网,有一些癌细胞就是喜欢在它们周围安家,找到机会就钻到神经、血管或淋巴管里。癌细胞一旦侵入成功,就如同上了“高速公路”,沿着这些网络游走,手术即使切除了原发灶,癌细胞也能跑到手术切不到的地方。

肿瘤患者癌栓发生率达40%~60%[1],发生了神经侵犯、脉管癌栓虽然还不是肿瘤转移的“实锤”,但预示着风险已经升高。
化疗无法兜底,还能怎么办?
罗女士发现病情还在进展后,对接下来的治疗开始迷茫:化疗已经做了8疗程,如果继续化疗一方面可能已经耐药,另一方面累积毒性会不会反而弊大于利?如果不化疗还有什么能清除残留癌细胞的方法?

偶然的机会清华大学医学院免疫学张明徽教授的科普让她看到的希望,并迅速与张教授团队取得了联系。
张明徽教授的乐和新医团队在全面评估罗女士的病情和治疗情况后,快速锁定了患者手术+8次化疗后出现转移的原因:一方面与肿瘤侵袭强、高危风险多有关;另一方面就是免疫系统在手术、化疗后,已经处于极度消耗状态,无法完成正常的免疫监视(癌细胞清除)工作。
现在罗女士正是介入vNKT免疫细胞治疗的好时机,既可以清除体内残余的癌细胞,又能激活自身免疫力对抗肿瘤,改善肿瘤微环境。
于是2024年9月11日,罗女士进入vNKT细胞治疗,细胞回输后仅1个月,罗女士就因担心病灶继续扩大而提前复查,结果影像学惊喜看到17*15mm的病灶稳定住了,没有继续进展,这也坚定了她的治疗信心。

直至2025年10月末次随访,罗女士经过11个疗程的序贯个体化vNKT免疫细胞治疗,病情已经彻底稳定下来,她也顺利通关术后2年。

vNKT细胞免疫治疗
NKT细胞 (Natural killer T cell),是一种细胞表面既有T细胞受体TCR,又有NK细胞受体的特殊T细胞亚群,它兼具NK细胞和T细胞的重要特征,具有非特异性和特异性识别肿瘤细胞的双重能力,可以非常快速地杀伤肿瘤细胞。在NKT细胞亚群中,有一种个头更大、杀伤能力更强的特种兵,就是清华大学张明徽教授的实验团队发现的vNKT(Variant Natural Killer T)细胞。
这群vNKT细胞在体内的数量非常少,且不会轻易被激活。但是一旦被活化,却能以一当百,杀灭那些可能残存在体内无法被发现的肿瘤细胞。另外,研究还发现vNKT细胞具有双重抗肿瘤效应,不仅能够直接杀伤癌细胞,还会调节肿瘤组织内部的免疫微环境,杀伤抑制性免疫细胞MDSCs,打破肿瘤的免疫逃逸,重建正常免疫系统,进一步预防复发转移。
实验条件:有vNKT细胞存在的情况下,经过16个小时,近乎所有B16肿瘤细胞被杀死!
令她惊喜的是,vNKT免疫细胞治疗带给她的除了病情的稳定,还有生活质量的提升,完全没有疼痛困扰,精神、饮食、睡眠、体力也都与常人无异,癌症带给她的身体和精神恐惧正在走远。
结论与点评
罗女士的经历让我们看到,抗癌战争没有“万能药”,但永远有“最优解”。对于“不好惹”的肿瘤,虽然处于早期、进行了化疗,可能依然无法兜底,您的抗癌策略,值得一次更全面升级。

参考来源:
[1]TritschlerT, KraaijpoelN, Le GalG, et al. Venous thromboembolism: advances in diagnosis and treatment[j]. JAMA, 2018, 320(15): 1583-1594. DOI:10.1001/jama.2018.14346.